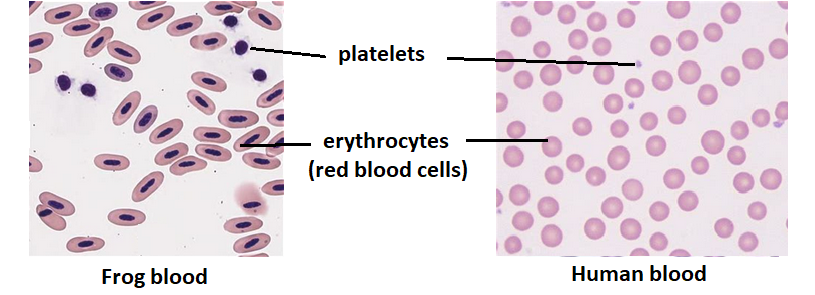

Blood and Blood Vessels
Students will investigate the work of Harvey and his discovery of the circulatory system. The structure and function of veins and arteries are also important components of this lesson and is the composition of blood, the names and roles of the different blood cells and the molecules carried by the blood plasma.
Lesson Description
Guiding Questions
What special adaptations do human erythrocytes have to enable them to pass easily through human blood capillaries?
How many other types of cells can you name in human blood?
Activity 1 - The discovery of the circulatory system by Harvey
How does blood flow round the body? How could you investigate that?
Galen studied anatomy in Italy with Fabricus who had wondered why veins had valves, there was no explanation for them. At the time it was thought that the blood only flowed away from the heart. An idea suggested by Galen, the Greek philosopher 1300 years before.
These
Introductory slides show how Harvey's evidence changed thinking about the flow of blood in the body.
Having read the slides above about Harvey's discovery of blood circulation answer the following question.
This is a question which links the Biology content to the Nature of Science.
Nature of science question
- The work of Harvey on blood circulation illustrates an important principal of the Nature of Science, a theory is never 100% certain as there is always a possibility that new evidence will falsify the theory.
Outline two pieces of evidence which Harvey used to support his ideas about circulation and falsify the old ideas of Galen.
(2 marks)
...........................................................................................................................
...........................................................................................................................
..........................................................................................................................
Click the eye icon below to reveal a model answer.
Model answer:
Experiments showed that blood flowed back to the heart.
These included the following:
- Fish hearts having their veins tied. The hearts emptied of blood, then refilled when the tie was removed.
- Blood was shown flowing towards the heart in veins of a human arm.
- Calculations of blood volume and pulse rates showed that huge volumes of blood were leaving the heart
Activity 2 - Structure of Arteries and veins
Look at the gallery of images of blood vessels. Then answer the questions on the short worksheet below.
Answer the questions on the
Artery and vein worksheet below.
Activity 3 Composition of the Blood
Using prepared slides of blood try to identify the number of different types of cells in the blood. If you haven't god real slides available take a look at this great Exploratorium blood cell feature - including a nice video.
Complete the questions on the
Blood composition student sheet
Teachers notes
Model answers for the activity 2 worksheet on blood vessels can be found here: Blood vessels - model answers
Model answers for activity 3 can be found here: Composition of blood - model answers
These links contain resources about the work of William Harvey on the circulation of blood
Listen to an extract from the in our Time podcast from the BBC. about Blood and the ideas at the time of Harvey. They make his discoveries even more impressive. Biography on the BBC
There are some interesting resources on blood histology and the functions of different blood cells:
IB Docs (2) Team


